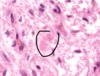
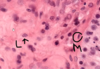

Lab 6 Flashcards
(149 cards)
Endocrine pancreas cells
Pancreatic acini (with exocrine cells) - dark purple
Pancreatic islet (with endocfine cells) - light purple

Pineal gland - identifying feature
Brain sand

Pineal gland - general

Neurohypophysis vs pineal gland
Neurohypophysis:
• Hormone release (oxytocin, ADH)
- Produced in Hypothalamus
- Pituicytes
- Herring Bodies
Pineal Gland
• Hormone production and release (Melatonin)
- Pinealocytes
- Brain Sand (corpora arenacea)

Islet of Langerhans (endocrine pancreas), surrounded by serous acini (exocrine pancreas)
Assume that most cells in middle of islet are beta and cells at periphery of islet is alpha cells

Alpha and beta cells in islet of Langerhans
Allows differentiation bw alpha and beta cells in islet of Langerhans. Beta cells stain more purple, alpha cells stain more pink. Most cells are beta cells, especially the ones in the middle

Beta cells in pancreas
Stains the insulin that is secreted by beta cells, beta cells stain darker

Pituitary - general parts
Lighter top region is pars nervosa, darker bottom region is pars distalis, middle is pars intermedia

Pituitary - remnants of Rathke’s pouch
At pars intermedia, the circles are remnants of Rathke’s pouch

Pars nervosa of pituitary consists of neuropil, pituicytes, endothelial cells, fenestrated capillaries, Herring bodies
Pars nervosa: neuropil is wispy material, most nuclei belong to pituicytes, some endothelial cells near RBC, fenestrated capillaries, identifying feature: pink blob called Herring bodies
Pars distalis of pituitary: Chromophobes, Basophils, Acidophils
Pars distalis: Chromophobes (don’t stain very intensely, not much color, already released all their hormones). Basophils (stain very dark, basophilic), Acidophils (stains very eosinophilic). Diff regions of pars distalis will have diff proportions of these 3 cell types

Pituitary - pars distalis and pars nervosa
Pars distalis is colorful. Lighter staining pars nervosa.

Pituitary - Pars nervosa: fenestrated capillary, neuropil, Herring body

Pituitary - Pars intermedia
Pars intermedia: remnants of Rathke’s pouch

Pituitary - Pars distalis: Acidophils, chromophobes

Pituitary - pars distalis: basophils

Pineal gland - pinealocytes, interstitial cells, brain sand
Pineal gland: made of nervous tissue, nuclei belong to one of 2 cell types. Larger nuclei that stain lighter belong to pinealocytes (make melatonin). Darker, elongated nuclei are interstitial cells. Brain sand (aggregates of calcified secretions and calcified ECM)

Pineal gland - B&W

Pars nervosa: pituicytes, herring bodies

Pineal gland: pinealocytes, brain sand ( corpora arenacea )

Pituicyte of pars nervosa

Pars nervosa of pituitary gland

Acidophils
Acidophils, secretes growth hormone and prolactin

Pinealocytes of pineal gland